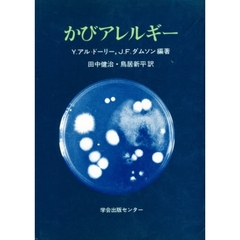
かびアレルギー

アレルギー
条件を絞り込んで探す
- 角田和彦/著 (9)
- 主婦の友社/編 (7)
- 吉野丈夫/著 (5)
- 富岡玖夫/〔ほか〕編集 (4)
- 斎藤洋三/著 (4)
- 梅崎和子/著 (4)
- 眞鍋穰/著 (4)
- 真鍋穣/著 (4)
- 久保道徳/著 (3)
- 塩川優一/著 (3)
- 大塚博邦/著 (3)
- 小川秀夫/監修 山木うさぎ/マンガ (3)
- 山本博意/著 (3)
- 戸田浄/著 (3)
- 松延正之/著 (3)
- 梁哲宗/著 (3)
- 水嶋丈雄/監修 主婦の友社/編 (3)
- 永倉俊和/監修 主婦の友社/編 (3)
- 渡辺雄二/著 (3)
- 菊池新/著 (3)
- 赤嶺福海/著 (3)
- 黒沢元博/著 (3)
- 上野川修一/著 (2)
- 上野紘郁/著 (2)
- 中川栄一/著 (2)
- 中川武正/編集 (2)
- 丹羽正幸/著 (2)
- 丹羽靭負/著 (2)
- 久郷晴彦/著 (2)
- 佐守友仁/著 (2)
- 佐藤のり子/著 (2)
- 佐野靖之/著 (2)
- 前田裕二/著 (2)
- 北原静夫/著 (2)
- 千葉友幸/著 平馬直樹/著 (2)
- 和合治久/著 (2)
- 大久保公裕/著 (2)
- 奥平博一/著 (2)
- 宮本昭正/監修 牧野荘平/〔ほか〕編集 (2)
- 宮本昭正/著 (2)
- 小倉英郎/監修 小倉由紀子/監修 アレルギーの子を持つ親の会「かたつむり」/編 (2)
- 山下明男/著 (2)
- 山崎太/著 (2)
- 岸本和裕/著 (2)
- 岸田勝/著 (2)
- 市川晶子/著&マンガ (2)
- 広瀬俊一/編集 橋本博史/編集 (2)
- 弁野義己/著 (2)
- 戸谷誠之/編 鳥居新平/編 (2)
- 橋本博史/著 (2)
- 正木拓朗/著 (2)
- 永田良隆/〔ほか〕著 (2)
- 江部康二/著 (2)
- 河野泉/〔ほか〕共著 (2)
- 河野泉/著 (2)
- 浦長瀬昌宏/著 (2)
- 海老澤元宏/監修 (2)
- 深川和己/著 (2)
- 清益功浩/著 (2)
- 渡辺勝行/著 (2)
- 犬山康子/著 佐野正行/監修 (2)
- 生活情報研究会/編 (2)
- 田中貴子/著 (2)
- 甲田光雄/著 (2)
- 石塚洋一/著 (2)
- 磯辺善成/著 (2)
- 竹中恭子/著 (2)
- 西原克成/著 (2)
- 西田元彦/著 (2)
- 赤城智美/著 吉村史郎/著 (2)
- 赤峰勝人/著 (2)
- 順天堂大学医学部/編 (2)
- 高橋夫紀子/著 (2)
- 黒木 睦彦 監 (2)
- えんどうかおり/作・絵 西川嘉英/監修 (1)
- こばやしけいこ/著 (1)
- ちびシャトル/文・絵 (1)
- ぬまじりよしみ/作 佐藤健二/監修 (1)
- アトピッ子地球の子ネットワーク/著 (1)
- アトピーなんか飛んで行け!の会/編 (1)
- アトピー・ステロイド情報センター/編 (1)
- アトピー・ネットワーク・リボーン/著 (1)
- アトピー環境研究会・名古屋/編 (1)
- アド/著 進藤加奈子/訳 (1)
- アレルギーネットワーク/編 (1)
- ウパディヤヤ・カリンジェ・クリシュナ/共著 加藤幸雄/共著 (1)
- ケアリー・ナドー/著 スローン・バーネット/著 山田美明/訳 (1)
- シルヴィア・ゴールドファーブ/著 中田良/日本語版監修 藤野邦夫/訳 (1)
- スザンナ・オリヴィエ/著 射場今日子/共訳 宗寛博/共訳 武岡幸代/共訳 庭野淳子/共訳 堀込奈穂子/共訳 山藤元史/共訳 古川奈々子/監訳 (1)
- セロン・G・ランドルフ/著 ラルフ・W・モス/著 河野泉/訳 石川広己/訳 (1)
- テリーサ・マクフェイル/著 坪子理美/訳 (1)
- ニットークリエイティブ株式会社編集部/編集 (1)
- ノーマン・カズンズ/著 松田銑/訳 (1)
- ピーター・ラデツキー/著 久保儀明/訳 楢崎靖人/訳 (1)
- ルイボスティーとアトピー研究会/編 (1)
- 三好彰/編 (1)
- 三好彰/編著 (1)
- 三宅健/著 (1)
- 三宅和久/原作 馬場民雄/作画 (1)
- 三心堂出版社/編 (1)
著者
- メディア・クライス (26)
- 現代書林 (22)
- 主婦の友社 (20)
- 農山漁村文化協会 (17)
- 芽ばえ社 (16)
- 講談社 (16)
- 法研 (12)
- メディカルレビュー社 (11)
- 金原出版 (11)
- 保健同人社 (10)
- 主婦と生活社 (9)
- メタモル出版 (8)
- 医薬ジャーナル社 (8)
- 文芸社 (8)
- ごま書房 (7)
- 小学館 (7)
- 北隆館 (6)
- 桐書房 (6)
- リヨン社 (5)
- 世界文化社 (5)
- 女子栄養大学出版部 (5)
- 家の光協会 (5)
- 幻冬舎メディアコンサルティング (5)
- 日本医事新報社 (5)
- マキノ出版 (4)
- 南江堂 (4)
- 成美堂出版 (4)
- 日本評論社 (4)
- 日東書院本社 (4)
- 柘植書房新社 (4)
- 永岡書店 (4)
- あおば出版 (3)
- せせらぎ出版 (3)
- ハート出版 (3)
- ベストセラーズ (3)
- ユリシス・出版部 (3)
- 先端医学社 (3)
- 創元社 (3)
- 医歯薬出版 (3)
- 史輝出版 (3)
- 合同出版 (3)
- 婦人生活社 (3)
- 実業之日本社 (3)
- 彩流社 (3)
- 新泉社 (3)
- 白誠書房 (3)
- 第一出版 (3)
- 近代出版 (3)
- いちい書房 (2)
- かざひの文庫 (2)
- かんき出版 (2)
- ごま書房新社 (2)
- みずうみ書房 (2)
- みらい (2)
- アスペクト (2)
- コモンズ (2)
- ナツメ社 (2)
- ブイツーソリューション (2)
- ライフサイエンス出版 (2)
- 三心堂出版社 (2)
- 三笠書房 (2)
- 健友館 (2)
- 健康ジャーナル社 (2)
- 医学書院 (2)
- 医薬経済社 (2)
- 同文書院 (2)
- 外来アレルギー懇話会 (2)
- 子どもの未来社 (2)
- 学生社 (2)
- 宝島社 (2)
- 廣済堂出版 (2)
- 悠飛社 (2)
- 新星出版社 (2)
- 新興医学出版社 (2)
- 日本医学出版 (2)
- 日本実業出版社 (2)
- 日本文芸社 (2)
- 日本経済新聞出版社 (2)
- 早稲田出版 (2)
- 時事通信出版局 (2)
- 暮しの手帖社 (2)
- 本の泉社 (2)
- 毎日新聞出版 (2)
- 池田書店 (2)
- 現代書館 (2)
- 知玄舎 (2)
- 第三書館 (2)
- 総合科学出版 (2)
- 翔雲社 (2)
- 自由国民社 (2)
- 診断と治療社 (2)
- 青春出版社 (2)
- 風媒社 (2)
- 鳥影社 (2)
- 1万年堂出版 (2)
- Gakken (2)
- Jパブリッシング (2)
- NECメディアプロダクツ (2)
- NHK出版 (2)
- あゆみ出版 (1)
出版社
セロン・G・ランドルフ/著 ラルフ・W・モス/著 河野泉/訳 石川広己/訳 (本・コミック)
販売価格: 2,893円 (税込3,182.30円)
14 ポイント
![]()